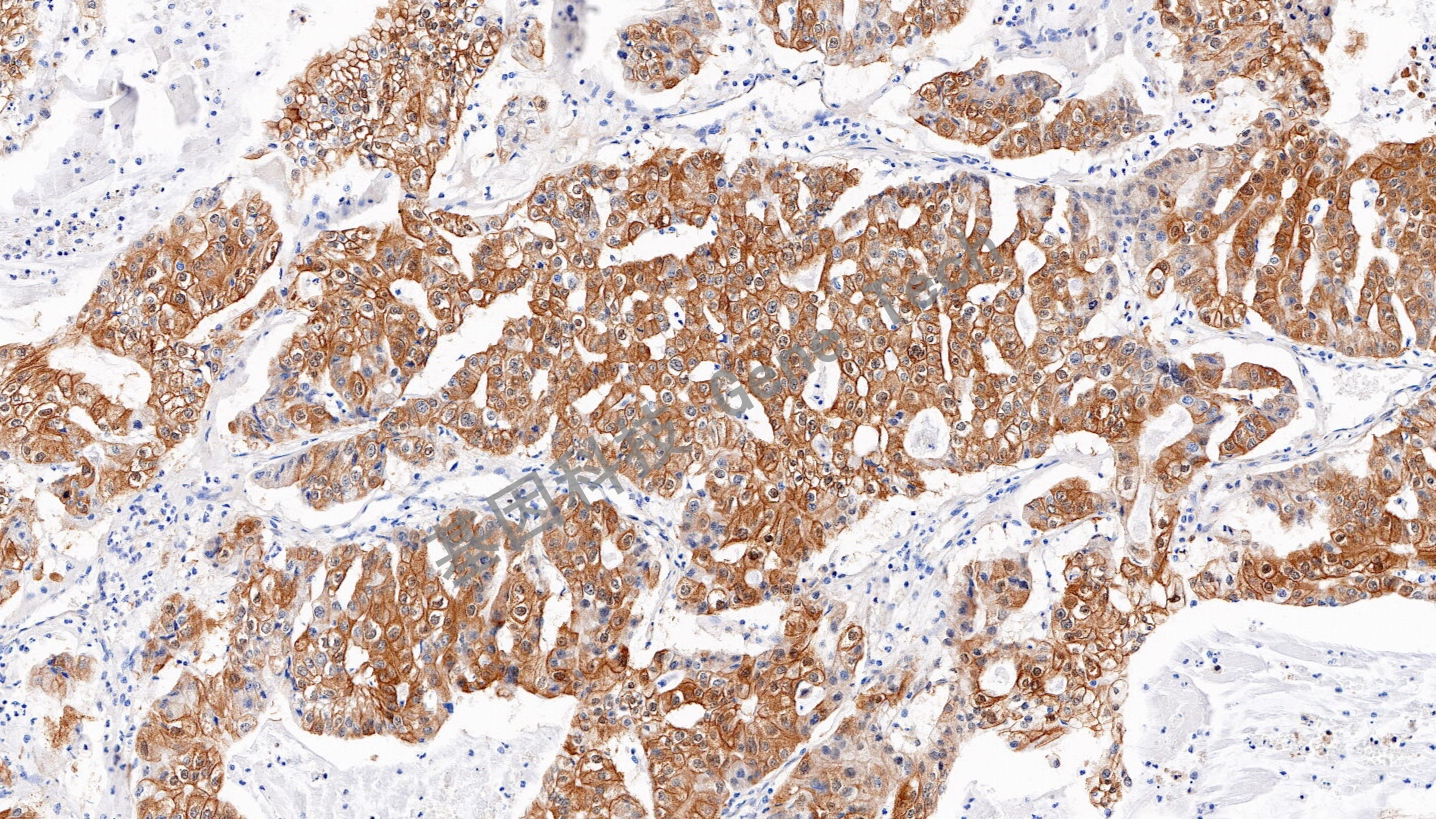
1694753645886897.jpg

产品中心
Products
AKR1B10 兔抗人 AKR1B10 抗体试剂(免疫组织化学法)
浏览次数:394 发布时间:2023-09-11
| 沪闵械备20230619号 | ||
| 克隆号:EPR14421 | 种属:兔 | 适用染色系统:GTvisionTM |
| 预处理:高pH热修复 | 阳性部位:细胞浆 | 阳性对照:肝癌 |
| 简介:醛酮还原酶家族1成员B10((aldo-keto reductase 1B10,AKR1B10),主要功能是还原醛酮类羰基化合物、促进脂质合成和调节视黄酸代谢。AKR1B10首先发现于肝癌中,在正常人体组织中主要表达于胃肠道组织,在其他组织中低表达或不表达。研究表明AKR1B10在肿瘤的发生发展过程中发挥重要的作用,在许多上皮性肿瘤中出现了过表达的现象,如乳腺癌、宫颈癌、肺癌等。因此AKR1B10可能成为肿瘤诊断非常有价值的分子标记物以及靶向治疗肿瘤的新靶点。 | ||
![]() | ||
| 肝癌石蜡切片,用 AKR1B10(GT2563)染色,细胞浆阳性,DAB 显色。 | ||
| 货号 | GT256302 | GT256307 |
| 规格 | 2.0ml | 7.0ml |